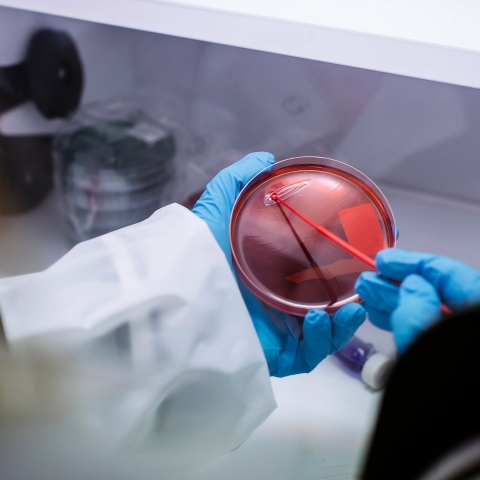
January 2020

High magnification material analysis
Location: Burnaby Building
Housed within the School of the Environment and Life Sciences, the Electron Microscopy and Microanalysis Unit provides expertise and support in advanced materials characterisation to students and researchers from across the University of Portsmouth, as well as regional industry.
Our laboratories contain state-of-the-art instrumentation, with dedicated technical and academic support. The laboratory includes wide-ranging capabilities for micro- to nano-scale characterisation of materials by scanning electron microscopy (SEM), and focused ion beam (FIB)-SEM. We specialise in microstructural analysis by electron backscatter diffraction (EBSD) and scanning transmission electron microscopy (STEM), as well as microchemical analysis by energy dispersive X-ray microscopy (SEM-EDS) and laser ablation inductively-coupled-plasma mass spectrometry (LA-ICP-MS).
Explore our Electron Microscopy and Microanalysis Unit

Access Scanning electron microscopy (SEM) sample holders
Discover our sample holders, available for SEM analysis.

Benefit from efficient correlative microscopy
Our chambers enter a high-performance motorized stage that allows for efficient correlative microscopy and a wide range of analyses.

Capture high-resolution images
One of our five SEMs offers high resolution imaging and microanalysis capabilities.

Analyse nanoscale chemical and structural properties
Our Zeiss EVO 10MA SEMs is optimised for micro- to nano-scale chemical and structural analyses.

Obtain high-performance measurements over large areas
Our two-volume sample cell allows for high-performance measurements over very large areas.
Equipment and amenities
Our Tescan Amber FIB-SEM was installed in 2024, bringing ultra-high resolution (UHR) imaging and precise Ga+ FIB milling capabilities to EMMU. The system offers outstanding SEM imaging capabilities at 1-30 keV, scanning transmission electron microscope (STEM) imaging, and the FIB can be utilised for micro-sectioning, TEM/STEM liftouts, atom probe sample preparation and more. The system is also equipped with Oxford Symmetry S2 EBSD and Ultim Max EDS detectors for nanostructural and chemical characterization.
We have four scanning electron microscopes (SEM) equipped with a wide-range of detector types for analysis of a wide-range of materials under high- and low-vacuum conditions. These include systems with field-emission gun, LaB6 and tungsten electron sources, and detector systems for secondary electron (SE), backscattered electron (BSE), cathodoluminescence (CL), energy-dispersive X-ray (EDS) spectroscopy and electron backscatter diffraction (EBSD). The instruments are supported by dedicated sample preparation and coating equipment.
We specialize in micro- to nano-scale structural analysis of natural and manufactured materials by EBSD, using an Oxford Instruments Symmetry S2 detector and Aztec software.
The Mass Spectrometry and Laser Ablation Laboratory hosts state-of-the-art equipment to measure trace elements and isotope ratios in a wide range of natural and industrial materials. These include a NERC funded UV-femtosecond LA-LIBS system and 193 nm nanosecond excimer laser ablation system, either of which can be coupled to an Agilent 8900 ICP-MS/MS and/or Nu Plasma MC-ICP-MS.
We have a range of light microscopes that can be used in support of Electron Microscopy and Microanalysis Unit activities. These include stereo, transmitted polarizing light and reflected light microscopes.
Research
Our facilities support many research groups and provide training and consultancy opportunities for academic and industrial collaborators in the areas of:
- Biological Sciences
- Earth and Environmental Sciences
- Mechanical Engineering
- Pharmacy, Pharmacology and Biomedical Sciences
- Geography
- Planetary Science
- Forensic Science
Contact us
For more information, please contact Prof. James Darling, Director of the Electron Microscopy and Microanalysis Unit:
Email: james.darling@port.ac.uk
Related facilities
Physical Geography and Meteorology Laboratories
Use the latest physical and meteorological equipment in our labs, including a rainfall simulator and automatic weather stations.

Biophysical laboratories
Use professional-standard equipment to explore how the structures and functions of molecules change under different conditions.
Institute of Marine Sciences
Explore the marine ecosystems of the Solent European Marine Site at our shoreside marine station, complete with floating research platform, £2 million aquarium and laboratory suite.

Where to find us
Electron Microscopy and Microanalysis Unit
Burnaby Building,
Burnaby Road,
Portsmouth,
PO1 3QL